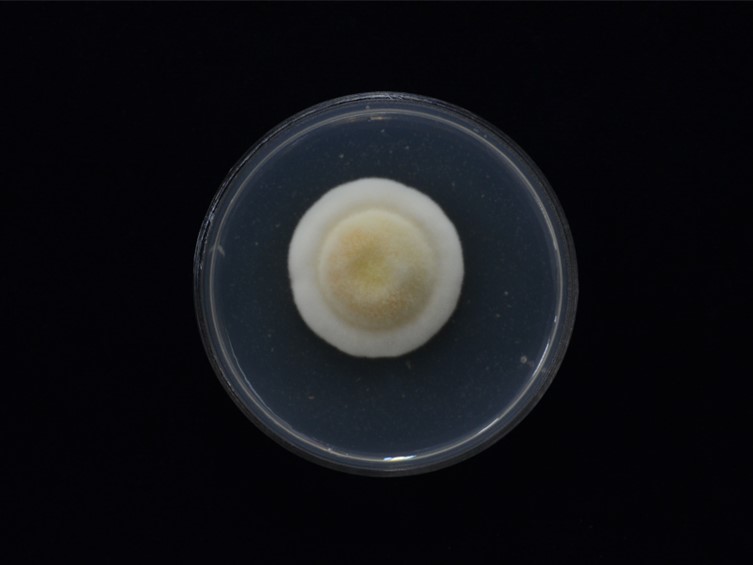

Holotype:
THAILAND, Chiang Mai Province, Doi Inthanon National Park, 8 Oct. 2012, K. Tasanathai, A. Khonsanit, W. Noisripoom, P. Srikitikulchai, R. Promharn, holotype BBH 36132, ex-type living culture BCC 55812.
Habitat:
Leaf litter.
Host:
Lepidopteran larva and pupa.
Description:
 Stromata multiple, arising from head, thorax and abdomen of insect hosts, orange to reddish-orange, cylindrical, 6-25 mm long and 2-4 mm wide. Fertile part cylindrical to clavate, approximately half of stroma, 3-5 mm wide, orange yellow.
Stromata multiple, arising from head, thorax and abdomen of insect hosts, orange to reddish-orange, cylindrical, 6-25 mm long and 2-4 mm wide. Fertile part cylindrical to clavate, approximately half of stroma, 3-5 mm wide, orange yellow.  Perithecia semi-immersed, half-embedded, ovoid, 600-720 × 220-420 μm.
Perithecia semi-immersed, half-embedded, ovoid, 600-720 × 220-420 μm.  Asci cylindrical, eight-spored, 450-600 × 4-6 μm. Ascospores hyaline, 400-550 μm long, dissociating into 128 part-spores, cylindrical, 3-4 × 1-1.5 μm. Anamorph: phialidic, cylindrical.
Asci cylindrical, eight-spored, 450-600 × 4-6 μm. Ascospores hyaline, 400-550 μm long, dissociating into 128 part-spores, cylindrical, 3-4 × 1-1.5 μm. Anamorph: phialidic, cylindrical.
Culture characteristics:
Colony on PDA attaining a diam of 30 mm in 30 d, cottony with high mycelium density, white to pale yellow. Phialides arising from aerial hyphae, solitary, cylindrical at the base tapering to the apex, 12–20 × 1.5–3 μm. Conidia hyaline, cylindrical, smooth, one-celled, 4–9 × 1.5–2 μm.
Colony on PDA attaining a diam of 30 mm in 30 d, cottony with high mycelium density, white to pale yellow. Phialides arising from aerial hyphae, solitary, cylindrical at the base tapering to the apex, 12–20 × 1.5–3 μm. Conidia hyaline, cylindrical, smooth, one-celled, 4–9 × 1.5–2 μm.
Reference:
Mongkolsamrit S, Noisripoom W, Tasanathai K, et al. (2020). Molecular phylogeny and morphology reveal cryptic species in Blackwellomyces and Cordyceps (Cordycipitaceae) from Thailand. Mycological Progress 19: 957–983.
DOI: https://doi.org/10.1007/s11557-020-01615-2Species |
Strain |
Compound |
Pubchem CID |
Biological activity |
Reference |
|---|
|
Strain |
ITS | LSU | RPB1 | RPB2 | TEF1 |
|---|---|---|---|---|---|
| BCC 55812 | MT000706 | MT003041 | MT017815 | MT017832 | |
| BCC 56302 | MT000705 | MT003040 | MT017814 | MT017831 | MT017853 |
| BCC 79828 | MT000707 | - | MT017816 | MT017833 | MT017854 |